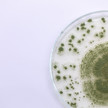
FDA: Indikationserweiterung für Isavuconazol

Thema: BfArM/EMA/FDA
Artikel zum Thema
HIV-Medikamentenversorgung BfArM: PrEP-Verfügbarkeit bis Ende April gesichert
Hersteller meldeten zuletzt Lieferengpässe bei einem HIV-Medikament. Die Versorgung von zehntausenden Nutzern in Deutschland war bedroht. Nun gibt das... Mehr»
Sachverständigenausschuss Desogestrel bleibt verschreibungspflichtig
Die Entscheidung ist eindeutig. Der Sachverständigenausschuss (SAV) für Verschreibungspflicht hat sich heute gegen einen OTC-Switch von Desogestrel... Mehr»
Heute im Sachverständigenausschuss Kommt der OTC-Switch für Desogestrel?
Heute kommt der Sachverständigenausschuss für Verschreibungspflicht zusammen. Auf der Agenda steht der OTC-Switch von Desogestrel 75µg zur oralen Anwendung. Mehr»
16,71 statt 24,48 Milliarden Euro Haushalt 2024: BMG-Gesamtetat sinkt um ein Drittel
Bundesgesundheitsminister Karl Lauterbach (SPD) soll in diesem Jahr nur noch 16,71 Milliarden Euro ausgeben können. 2023 standen dem Gesundheitsministerium rund... Mehr»
Negative Effekte durch MK-7? Vitamin K2: Höchstmengen beachten
Vitamin K ist nicht nur eine Verbindung, sondern ein Oberbegriff für verschiedene Verbindungen. Diese spielen unter anderem eine entscheidende Rolle bei der... Mehr»
Lieferengpass Salbutamol: Versorgungsmangel und erleichterter Import
Der Lieferengpass bei Salbutamol Dosier-Aerosolen hat sich bereits im Sommer vergangenen Jahres angekündigt. Jetzt hat das Bundesgesundheitsministerium einen... Mehr»
Kein Medizinprodukt Silbernitrat-Nasentropfen: Im Zweifel ein Arzneimittel
Ist unklar, ob ein Präparat als als Arzneimittel oder als Medizinprodukt einzustufen ist, muss der Hersteller nachweisen, dass die niedrigeren Voraussetzungen... Mehr»
Sichelzellkrankheit Genscheren-Therapie: Ema empfiehlt Zulassung von Casgevy
Die europäische Arzneimittelbehörde Ema empfiehlt erstmals die bedingte Zulassung einer auf der Genscheren-Technologie Crispr basierenden Therapie. Casgevy sei... Mehr»
Pilzerkrankungen FDA: Indikationserweiterung für Isavuconazol
Basilea Pharmaceutica AG, ein biopharmazeutisches Unternehmen mit bereits vermarkteten Produkten und dem Ziel, Patienten zu helfen, die an schweren Infektionen... Mehr»
BfArM analysiert Zahlen Kinderantibiotika: In Apotheken lagert Bedarf für Monate
In der vergangenen Infektionssaison waren Kinderantibiotika oft Mangelware. Apotheken, Hersteller und Ärzt:innen blicken in eine düstere Erkältungssaison... Mehr»
Medien zum Thema
- 1
- 2